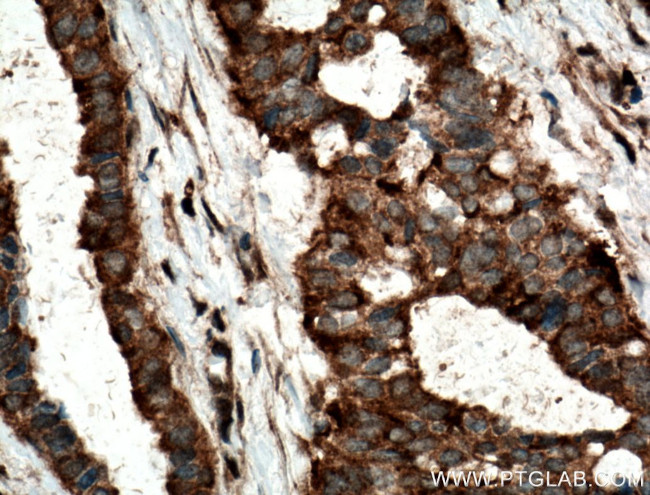
TOMM6 Antibody in Immunohistochemistry (Paraffin) (IHC (P))

Search
Proteintech
TOMM6 Polyclonal Antibody
{{$productOrderCtrl.translations['antibody.pdp.commerceCard.promotion.promotions']}}
{{$productOrderCtrl.translations['antibody.pdp.commerceCard.promotion.viewpromo']}}
{{$productOrderCtrl.translations['antibody.pdp.commerceCard.promotion.promocode']}}: {{promo.promoCode}} {{promo.promoTitle}} {{promo.promoDescription}}. {{$productOrderCtrl.translations['antibody.pdp.commerceCard.promotion.learnmore']}}
产品信息
16689-1-AP
种属反应
宿主/亚型
分类
类型
抗原
偶联物
形式
浓度
规格
纯化类型
保存液
内含物
保存条件
运输条件
产品详细信息
Immunogen sequence: MASSTVPVS AAGSANETPE IPDNVGDWLR GVYRFATDRN DFRRNLILNL GLFAAGVWLA RNLSDIDLMA PQPGV (1-74 aa encoded by BC018624)
靶标信息
TOMM6, also named as OBTP and TOM6, is a part of the preprotein translocase complex of the outer mitochondrial membrane (TOM complex).
仅用于科研。不用于诊断过程。未经明确授权不得转售。
篇参考文献 (0)
生物信息学
蛋白别名: Mitochondrial import receptor subunit TOM6 homolog; over-expressed breast tumor protein; Overexpressed breast tumor protein; Overexpressed breast tumor protein homolog; prickle homolog 4; Translocase of outer membrane 6 kDa subunit homolog; translocase of outer mitochondrial membrane 6 homolog; translocase of outer mitochondrial membrane 6 homolog (yeast)
基因别名: 1110002E23Rik; AI663970; OBTP; Prickle4; TOM6; TOMM6
UniProt ID: (Human) Q96B49, (Mouse) Q9CQN3
Entrez Gene ID: (Human) 100188893, (Rat) 681123, (Mouse) 66119